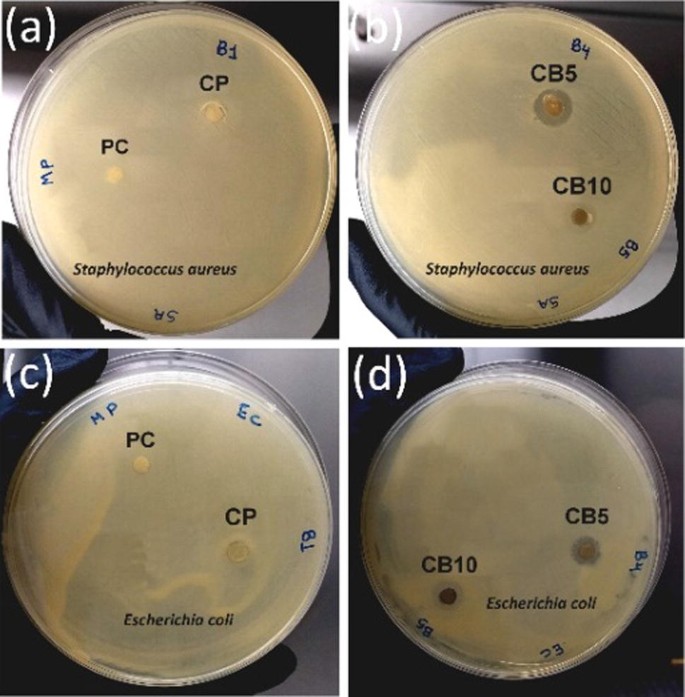
Synthesis And Characterization Of Ag Doped 45s5 Bioglass And Chitosan 45s5 Ag Biocomposites For Biomedical Applications Springerlink

Your 300 gram brp kg images are available in this site. 300 gram brp kg are a topic that is being searched for and liked by netizens today. You can Find and Download the 300 gram brp kg files here. Download all royalty-free vectors.
If you’re searching for 300 gram brp kg images information linked to the 300 gram brp kg topic, you have come to the right blog. Our site frequently provides you with hints for downloading the highest quality video and picture content, please kindly search and locate more informative video articles and images that match your interests.
300 Gram Brp Kg. 300 grams 066138678655463 pounds. Kgm3lbyd3 1 kgm3 1685555 lbyd3 kgm3lbgal UK 1 lbgal UK 99776397913856 kgm3 kgm3lbft3 1 lbft3 1601846336974 kgm3 kgm3lbgal US 1 lbgal US 11982642730074 kgm3 kgm3ozin3 1 ozin3 17299940439319 kgm3 kgm3ozft3 1 ozft3 10011539606087 kgm3 kgm3ozyd3 1 kgm3 26968879 ozyd3. Ihr Baby in SSW 28. Für die ausgewählte Versandadresse sind kostenlose Rücksendungen verfügbar.
 Battery For Mz Muz 6v 6n11a 1b Models Es Ets Ts 125 150 250 19 95 From motorsportgoetz.com
Battery For Mz Muz 6v 6n11a 1b Models Es Ets Ts 125 150 250 19 95 From motorsportgoetz.com
You need to know what you are converting in order to get the exact cups value for 300 grams. Die Maße können sich dabei von Hersteller zu. But even if there is no exact conversion rate converting 300 grams to cups here you can find the conversions for the most searched for food items. 100000 Gram 100 Kilo. Je nach Sicherheitsbedürfnis genügen auch E2-Prüfgewichte mit DKD. 2 kg 4 ons 500 gram brp kg.
Gesuchtes Prüfgewicht hat die Gewichtsgröße 2 kg.
Ausnahme Analysenwaagen Ablesbarkeit d 01mg. How much does 300 grams weigh in kilograms. Die Maße können sich dabei von Hersteller zu. Learn more about BRPs world-renowned vehicles from the BRP official website. 1 g to kg 0001 kg. Ihr Baby in SSW 28.
 Source: pinterest.com
Source: pinterest.com
1790 KOSTENLOSE Rücksendungen. 300 grams 066138678655463 pounds. 50 Gram 005 Kilo. Ihr Baby in SSW 24. April 2019 2 11 Report.
 Source: pinterest.com
Source: pinterest.com
Ihr Baby in SSW 24. Ihr Baby in SSW 29. Diesen Artikel kostenlos zurücksenden. 10 0001 kilogram Jadi 1 gram 0001 kilogram Lalu jika ada pertanyaan lagi misalnya 15 kg 4 kg 12 kg 22 kg berapa gram. 31 von 5 Sternen 2 Sternebewertungen.
 Source: pinterest.com
Source: pinterest.com
100 g to kg 01 kg. Ihr Baby in SSW 24. How much does 300 grams weigh in kilograms. Sebanyak 300 gram diambil untuk menyediakan tamu. Ihr Baby in SSW 28.
Source: link.springer.com
Source: link.springer.com
It is the approximate weight of a cube of water 10 centimeters on a side. Kgm3lbyd3 1 kgm3 1685555 lbyd3 kgm3lbgal UK 1 lbgal UK 99776397913856 kgm3 kgm3lbft3 1 lbft3 1601846336974 kgm3 kgm3lbgal US 1 lbgal US 11982642730074 kgm3 kgm3ozin3 1 ozin3 17299940439319 kgm3 kgm3ozft3 1 ozft3 10011539606087 kgm3 kgm3ozyd3 1 kgm3 26968879 ozyd3. 25000 Gram 25 Kilo. 30 Gram 003 Kilo. 250 Gram 025 Kilo.
 Source: brainly.co.id
Source: brainly.co.id
Ihr Baby in SSW 25. 200 g to kg 02 kg. 6 Gram 0006 Kilo. Sebuah toples berisi 1 kg kopi. Please note that grams and cups are not interchangeable units.
 Source: pinterest.com
Source: pinterest.com
10 l Gasflasche 300 bar 140 970 cm. Diesen Artikel kostenlos zurücksenden. Die Maße können sich dabei von Hersteller zu. How many cups are 300 grams. Wonderfreeze 2 kg 4 ons 500 gram.
 Source: bukalapak.com
Source: bukalapak.com
A gram is the approximate weight of a cubic centimeter of water. 10 0001 kilogram Jadi 1 gram 0001 kilogram Lalu jika ada pertanyaan lagi misalnya 15 kg 4 kg 12 kg 22 kg berapa gram. Ihr Baby in SSW 28. Owen200403 2 kg 2000 g 4 ons. 300 grams 066138678655463 pounds.
 Source: in.pinterest.com
Source: in.pinterest.com
Setiap naik 1 tangga bagi 10. 500000 Gram 500 Kilo. 20 l Gasflasche 300 bar 204 970 cm. Ihr Baby in SSW 24. Kilograms to Grams conversion table.
 Source: pinterest.com
Source: pinterest.com
7 Gram 0007 Kilo. 500000 Gram 500 Kilo. Ihr Baby in SSW 23. 100 Gram 01 Kilo. Quick conversion chart of g to kg.
 Source: id.pinterest.com
Source: id.pinterest.com
9 Gram 0009 Kilo. Je nach Sicherheitsbedürfnis genügen auch E2-Prüfgewichte mit DKD. Wonderfreeze 2 kg 4 ons 500 gram. Ihr Baby in SSW 22. Sebuah toples berisi 1 kg kopi.
 Source: pinterest.com
Source: pinterest.com
31 von 5 Sternen 2 Sternebewertungen. Ihr Baby in SSW 29. 50 Gram 005 Kilo. Thus for 300 grams in kilogram we get 03 kg. Owen200403 2 kg 2000 g 4 ons.
 Source: mdpi.com
Source: mdpi.com
A gram is the approximate weight of a cubic centimeter of water. Für die ausgewählte Versandadresse sind kostenlose Rücksendungen verfügbar. 10 0001 kilogram Jadi 1 gram 0001 kilogram Lalu jika ada pertanyaan lagi misalnya 15 kg 4 kg 12 kg 22 kg berapa gram. 9 Gram 0009 Kilo. How many cups are 300 grams.

300 grams equals 1 14 cups water. Sebanyak 300 gram diambil untuk menyediakan tamu. Diesen Artikel kostenlos zurücksenden. 50 Gram 005 Kilo. 10 0001 kilogram Jadi 1 gram 0001 kilogram Lalu jika ada pertanyaan lagi misalnya 15 kg 4 kg 12 kg 22 kg berapa gram.
 Source: id.pinterest.com
Source: id.pinterest.com
The 300 g in kg formula is kg 300 0001. To convert 300 g to kg multiply the mass in grams by 0001. Nah agar bisa menjawab semua pertanyaan yang berhubungan dengan konversi satuan dari kg ke gram ada baiknya terlebih dulu. Gesuchtes Prüfgewicht hat die Gewichtsgröße 2 kg. Ihr Baby in SSW 28.
 Source: bisniskurir.com
Source: bisniskurir.com
2 kg 4 ons 500 gram brp kg. Thus for 300 grams in kilogram we get 03 kg. The 300 g in kg formula is kg 300 0001. See this conversion table below for precise 300. Gewichtsgröße im Waagendisplay bei CAL.
 Source: ar.pinterest.com
Source: ar.pinterest.com
Kilogramm kg in Gramm g umrechnen - Online-Rechner Kilogramm in Gramm Formeln Beispiele. 1000 g oder 2000 g. Gewichtsgröße im Waagendisplay bei CAL. 10000 Gram 10 Kilo. M g 5 kg 1000 5000 g.
 Source: bisniskurir.com
Source: bisniskurir.com
Please note that grams and cups are not interchangeable units. 50 l Gasflasche 200 bar 220 1640 cm. Diesen Artikel kostenlos zurücksenden. Setiap naik 1 tangga bagi 10. 30 Gram 003 Kilo.
 Source: motorsportgoetz.com
Source: motorsportgoetz.com
Passendes Prüfgewicht mit Toleranz 10 mg und Gewichtsgröße 2 kg findet man in der Genauigkeitsklasse F1. 250 Gram 025 Kilo. 31 von 5 Sternen 2 Sternebewertungen. 10 0001 kilogram Jadi 1 gram 0001 kilogram Lalu jika ada pertanyaan lagi misalnya 15 kg 4 kg 12 kg 22 kg berapa gram. The 300 g in kg formula is kg 300 0001.
This site is an open community for users to do sharing their favorite wallpapers on the internet, all images or pictures in this website are for personal wallpaper use only, it is stricly prohibited to use this wallpaper for commercial purposes, if you are the author and find this image is shared without your permission, please kindly raise a DMCA report to Us.
If you find this site beneficial, please support us by sharing this posts to your own social media accounts like Facebook, Instagram and so on or you can also bookmark this blog page with the title 300 gram brp kg by using Ctrl + D for devices a laptop with a Windows operating system or Command + D for laptops with an Apple operating system. If you use a smartphone, you can also use the drawer menu of the browser you are using. Whether it’s a Windows, Mac, iOS or Android operating system, you will still be able to bookmark this website.





